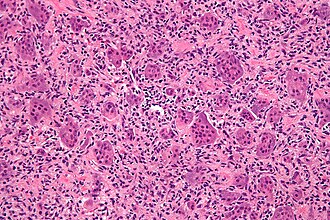

Giant cell tumour of bone
(Redirected from Malignant giant cell tumour)
Jump to navigation
Jump to search
| Giant cell tumour of bone | |
|---|---|
| Diagnosis in short | |
Giant cell tumour of bone. H&E stain. | |
|
| |
| LM | giant cells (usu. with >10 in the plane of section), mononuclear cells and small multinucleated cells with nuclei similar to those in the giant cells |
| LM DDx | other giant cell lesions |
| IHC | p63 +ve (patchy) |
| Site | bone, epiphysis usually |
|
| |
| Clinical history | usu. young adults (20-45 years old) |
| Signs | +/-immobility |
| Symptoms | +/-pain |
| Prevalence | uncommon ~ 5% of primary bone tumours |
Giant cell tumour of bone is an uncommon bone tumour.
General
Features:[1]
- Approximately 5% of primary bone tumours.
- Typical age: 20-45 years.
Clinical
- Location: growth plate of long bones.[2]
- May present with joint pain, immobility.
Note:
- Several types of giant cell tumours exist.
Microscopic
Features:[3]
- Giant cells with a large number of nuclei (usu. >10 in the plane of section).
- Usu. have prominent nucleoli.
- Mononuclear cells and small multinucleated cells with nuclei similar to those in the giant cells - key feature.
- +/-Hemosiderin deposition - not common.[4][5]
Notes:
- Giant cells typically present in abundance.
DDx:
- Giant cell lesions.
- Aneurysmal bone cyst - typically has spindle cells around the giant cells.
Images
- Giant cell tumour of bone - low mag.jpg
GCT of bone - low mag. (WC)
- Giant cell tumour of bone - intermed mag.jpg
GCT of bone - intermed. mag. (WC)
GCT of bone - high mag. (WC)
GCT of bone - very high mag. (WC)
IHC
See also
References
- ↑ Humphrey, Peter A; Dehner, Louis P; Pfeifer, John D (2008). The Washington Manual of Surgical Pathology (1st ed.). Lippincott Williams & Wilkins. pp. 648. ISBN 978-0781765275.
- ↑ Wülling, M.; Engels, C.; Jesse, N.; Werner, M.; Delling, G.; Kaiser, E. (Aug 2001). "The nature of giant cell tumor of bone.". J Cancer Res Clin Oncol 127 (8): 467-74. PMID 11501745.
- ↑ Klatt, Edward C. (2006). Robbins and Cotran Atlas of Pathology (1st ed.). Saunders. pp. 420. ISBN 978-1416002741.
- ↑ Aoki, J.; Moriya, K.; Yamashita, K.; Fujioka, F.; Ishii, K.; Karakida, O.; Imai, S.; Sakai, F. et al. "Giant cell tumors of bone containing large amounts of hemosiderin: MR-pathologic correlation.". J Comput Assist Tomogr 15 (6): 1024-7. PMID 1939753.
- ↑ Matsushige, T.; Nakaoka, M.; Yahara, K.; Kagawa, K.; Miura, H.; Ohnuma, H.; Kurisu, K. (Aug 2008). "Giant cell tumor of the temporal bone with intratumoral hemorrhage.". J Clin Neurosci 15 (8): 923-7. doi:10.1016/j.jocn.2007.03.013. PMID 18554912.
- ↑ Dickson BC, Li SQ, Wunder JS, et al. (April 2008). "Giant cell tumor of bone express p63". Mod. Pathol. 21 (4): 369–75. doi:10.1038/modpathol.2008.29. PMID 18311114.
- ↑ Alberghini M, Kliskey K, Krenacs T, et al. (January 2010). "Morphological and immunophenotypic features of primary and metastatic giant cell tumour of bone". Virchows Arch. 456 (1): 97–103. doi:10.1007/s00428-009-0863-2. PMID 20012988.